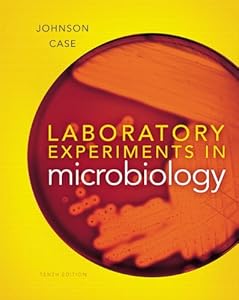

Publication Date: January 10, 2012 ISBN-10: 0,321,794,389 ISBN-13 :978-0321794383 Edition: 10
57 thoroughly class test and custom exercises, Microbiology Laboratory Experiements: Tenth Edition provides engaging in laboratory instruction execution the undergraduate basic microbiological techniques and applications in different fields, including the biological sciences, allied health science, agriculture, environment, nutrition, pharmacy, as well as various professional courses. The 10th edition also provides an update of the arts programs and full-color design, the the valuable microscopic entire each exercise. In addition, many of the illustrations have been re-rendered in a modern, real, three-dimensional style, so that students better visual. The laboratory report for each exercise has been enhanced, and new clinical applications, and the results of such assumptions or expectations. The experiments carried out improvements throughout the manual tenth edition includes a wide range of amendments to the reform movement the bacteria pGLO to introduce this important technology to students.
